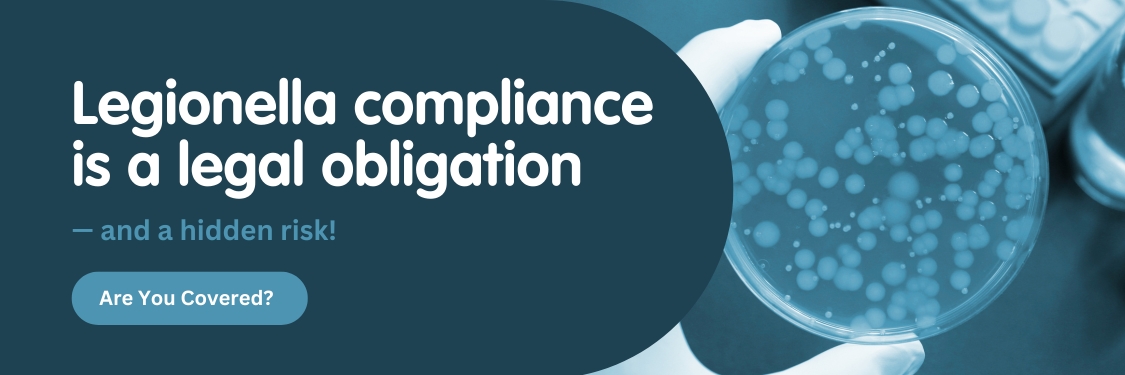

Legionella compliance is a legal obligation — and a hidden risk.
If your GP practice has water outlets (which it does), you’re legally required to manage the risk of Legionnaires’ disease under HSE ACOP L8 and CQC inspection standards. But many practices fall behind — either unaware of their responsibilities, or unsure how to fulfil them.
This quick, 5-point checklist helps you uncover blind spots, protect your patients, and pass your next CQC inspection with confidence.
5-Point Legionella Compliance Checklist for GP Surgeries
Use this checklist to get a snapshot of your current risk level.
1. Do you have a current, documented Legionella risk assessment?
- CQC inspectors will ask to see this.
- The HSE requires all healthcare premises to carry out a risk assessment (ref: HSE Legionella guidance).
- It should be reviewed every 2 years or when changes are made to water systems or usage.
- Cold water must be below 20°C within 2 minutes, hot must be at or above 50°C within 1 minute.
- Readings must be recorded in a logbook or digital monitoring system.
- Failure to monitor temperature is one of the top CQC non-compliance issues.
- Sinks in unused rooms or infrequently accessed areas can allow water to stagnate — a breeding ground for Legionella.
- These outlets must be flushed and the activity recorded, even if unused.
- A document detailing who is responsible, what checks are done, and what to do if a risk is identified.
- CQC expects evidence that the practice can demonstrate effective systems to assess and manage Legionella risk.
- This individual oversees the Legionella scheme and must understand their duties.
- Training should be formal and refreshed periodically — not just "on the job."
If You Answered ‘No’ or ‘Not Sure’ to Any Question...
Your practice may already be non-compliant, and this could put:
- Patients at avoidable risk
- Your CQC rating in jeopardy
But there’s a simple solution.
How We Can Help You Remain Compliant
We provide professional, UK-wide support to GP surgeries just like yours.
Legionella Risk Assessment Service
- Site visit and system inspection
- Temperature mapping
- Reporting and recommendations
- HSE and CQC aligned
- Written scheme for £350
Planned Preventative Management
- The Calibrated Water Thermometer Kit can be used monthly and will report if your water system is at risk of Legionella.
- The kit is to be used in house to comply with legislation but will not replace a full and proper Full Legionella Risk Assessment.
View the Calibrated Water Thermometer Kit Here
Print and record water temperatures monthly
- All employers who manage premises with hot/cold water systems and/or wet cooling systems, have a legal responsibility to identify any risk of contamination and to prevent or control it.
- These temperature logs are very important as they will be checked by CQC when they visit.
Click here to download the FREE log sheet. These records should be kept for a minimum of five years.
Full CQC Compliance Assessment Package
- Legionella, Fire Safety, Infection Control
- Tailored for GP practices